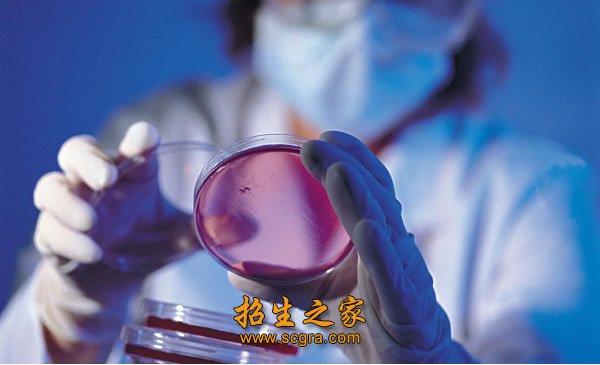
检验

-
- 专业介绍
- 图片展示
- 就业前景
- 在线报名
专业名称:高分子材料与工程专业
招生层次:大专+本科
培养目标:培养具有高分子材料与工程专业的基础知识,了解材料科学与工程领域相关的基础知识,能在高分子材料领域从事科学研究、教学、技术开发、工艺设计、生产及经营管理等方面工作,有较强的计算机应用能力和语言表达能力;身心健康并富有创新精神的高素质研究应用型专门人才。
主要课程:
主干学科:材料科学与工程
主要课程:有机化学、物理化学、高分子化学、高分子物理、聚合物流变学、聚合物成型工艺、聚合物加工原理、高分子材料研究方法
主要实践性教学环节:包括金工实习、生产实习、专业实验、计算机应用与上机实践、课程设计、毕业设计(论文)。
主要专业实验:高分子合成、高分子材料成型等
就业方向:可到石油化工、电子电器、建材、汽车、包装、航空航天、军工、轻纺及医药等系统的科研(设计)院所、企业从事塑料、橡胶、化纤、涂料、粘合剂、复合材料的合成、加工、应用、生产技术管理和市场开发等工作,以及为高新技术领域研究开发高性能材料、功能材料、生物医用材料、光电材料、精细高分子材料和其它特种高分子材料,也可到高等院校从事教学、科研工作。

高分子材料与工程专业培养适应社会需要,具有高分子材料与工程专业的基础知识和专业知识,了解材料科学与工程领域的相关专业知识,能在高分子材料的设计、合成、表征、改性、加工成型及应用等领域从事科学研究、技术开发、工艺设计、生产及经营管理等方面工作,具有较高计算机和外语水平,身心健康、素质优良、有创新精神的高级工程技术人才。
高分子材料与工程专业就业方向
从事材料专业的工程技术人员按工作性质可分为材料的研究、开发、生产和应用。这随着材料事业的发展有所不同。在七八十年代,有些学校,例如天津城市建设学院,主要培养从事硅酸盐材料生产的工程技术人员,充实到了有关工厂,对加强生产单位的技术力量,提高技术人员素质起到一定的作用。但是,随着天津市和与外省市交换培养的学生所在地材料生产厂技术力量趋于饱和,这方面人才需求量有了变化,现在在建筑行业从事材料应用、检测及材料管理工作的只占一半左右。
高分子材料与工程专业就业前景
关于这个专业在开始找工作时的情况:我在2006年11月份,已经找到了三个公司美的、格力漆包线、金川公司等。我自己感觉这个专业最近几年找到工作不是问题,关键是待遇好坏,我同学他们刚签工作时的薪水最高3000,可能和其他专业差了很多。 工作中:我只能拿我在金川公司工作的情况和你说说,在这个公司我干的是电线电缆生产的行业,现在在各个车间实习,最后从技术到管理。这个专业污染方面可能和我们主公司的重工业没法相提并论,但也存在着污染。如果在将来能够将技术和管理做好的话待遇方面也应该是可观的。
-

- 上一篇:应用化学专业
- 下一篇:石油化工生产技术专业












